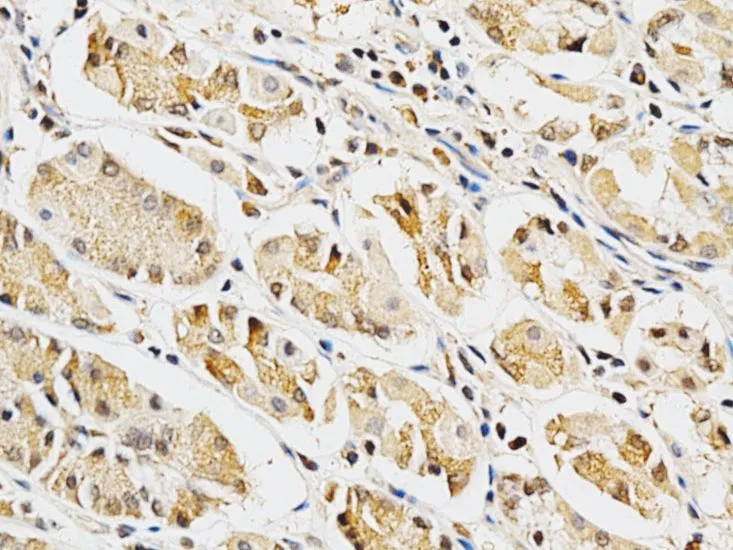
IHC-P analysis of human stomach tissue using GTX55633 Galectin 3 antibody. Dilution : 1:200

ICC/IF analysis of MCF7 cells using GTX55633 Galectin 3 antibody. Blue : DAPI
Galectin 3 antibody
GTX55633
ApplicationsImmunoFluorescence, ImmunoCytoChemistry, ImmunoHistoChemistry, ImmunoHistoChemistry Paraffin
Product group Antibodies
TargetLGALS3
Overview
- SupplierGeneTex
- Product NameGalectin 3 antibody
- Delivery Days Customer9
- Application Supplier NoteICC/IF: 1:20 - 1:50. IHC-P: 1:50 - 1:200. *Optimal dilutions/concentrations should be determined by the researcher.Not tested in other applications.
- ApplicationsImmunoFluorescence, ImmunoCytoChemistry, ImmunoHistoChemistry, ImmunoHistoChemistry Paraffin
- CertificationResearch Use Only
- ClonalityPolyclonal
- ConjugateUnconjugated
- Gene ID3958
- Target nameLGALS3
- Target descriptiongalectin 3
- Target synonymsCBP35, GAL3, GALBP, GALIG, L31, LGALS2, MAC2, galectin-3, 35 kDa lectin, IgE-binding protein, MAC-2 antigen, advanced glycation end-product receptor 3, carbohydrate-binding protein 35, epididymis secretory sperm binding protein, galactose-specific lectin 3, laminin-binding protein, lectin L-29, lectin, galactoside-binding, soluble, 3
- HostRabbit
- IsotypeIgG
- Protein IDP17931
- Protein NameGalectin-3
- Scientific DescriptionThis gene encodes a member of the galectin family of carbohydrate binding proteins. Members of this protein family have an affinity for beta-galactosides. The encoded protein is characterized by an N-terminal proline-rich tandem repeat domain and a single C-terminal carbohydrate recognition domain. This protein can self-associate through the N-terminal domain allowing it to bind to multivalent saccharide ligands. This protein localizes to the extracellular matrix, the cytoplasm and the nucleus. This protein plays a role in numerous cellular functions including apoptosis, innate immunity, cell adhesion and T-cell regulation. The protein exhibits antimicrobial activity against bacteria and fungi. Alternate splicing results in multiple transcript variants.[provided by RefSeq, Oct 2014]
- Storage Instruction-20°C or -80°C,2°C to 8°C
- UNSPSC12352203

![IHC-P analysis of human colon tissue using GTX22785 Galectin 3 antibody [A3A12]. Right : Primary antibody Left : Negative control without primary antibody Antigen retrieval : 10mM sodium citrate (pH 6.0) microwaved for 8-15 min Dilution : 1:100](https://www.genetex.com/upload/website/prouct_img/normal/GTX22785/GTX22785_1107_IHC-P_w_23060620_345.webp)